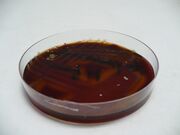
Streptococcus pneumoniae blood agar.jpg
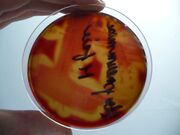
Streptococcus pneumoniae M-phase-blood agar-detail hemolysis.jpg
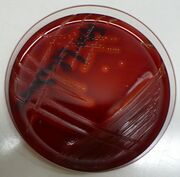
Streptococcus pyogenes-blood agar4mf4k.jpg
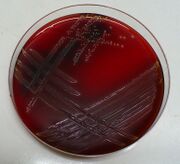
Streptococcus agalatiae-blood agarkkmk.jpg
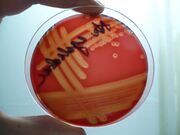
Streptococcus agalatiae-krevni agar-hemolysis.jpg

Streptococcus
thumb Streptococci - Gram staining The genus Streptococcus includes primary and secondary pathogenic bacteria. They occur as commensals on the mucous membrane of humans.
- MORPHOLOGY: G + cocci in pairs and chains, non-sporulating, immobile.
- METABOLISM: negative catalase test, are facultatively anaerobic and microaerophilic, may be capnophilic (CO2 promotes growth).
- OCCURRENCE: on the skin and mucous membranes of the respiratory, digestive and genital tracts as part of the normal microflora.
- CULTIVATION: grow on blood agar in small colonies, often with a hemolysis zone; they also grow in liver broth.
- MATERIAL COLLECTION: clinical material from purulent infections, cerebrospinal fluid, blood and sputum is collected for diagnosis.
Distribution[edit | edit source]
Alpha-hemolytic (right) and beta-hemolytic (left) streptococci growing on blood agar The genus includes a large number of species whose properties are quite different, so they are further divided into:
- 1. According to changes in blood agar
- beta-hemolytic (hemolysis)
- complete disruption of erythrocyte membranes, clearing of the soil around colonies of Streptococcus pyogenes, Streptococcus agalactiae Streptococcus dysgalactiae;
- alpha-hemolytic (viridizing) - Streptococcus pneumoniae, Streptococcus mutans, Streptococcus salivarius;
- gamma-hemolytic - no changes Streptococcus bovis, Streptococcus urinalis;
- 2. According to Lancefield
- serologically according to specific antigens
- antigen = specific polysaccharide substance C
- demonstrated only in β-hemolytic and some viridizing strains
- Antigen A–Z[1]
- 3. According to biochemical and physiological characteristics
- 4. According to pathogenicity and place of occurrence
- pyogenic (Streptococcus pyogenes, S. agalactiae, S. equi)
- oral = group of viridators
- enterococcie
- lactococci
- opportunistic - often members of the normal microflora of humans and animals
- obligate - S. pyogenes, S. agalacticae, S. pneumoniae
Representatives[edit | edit source]
Streptococcus pyogenes[edit | edit source]
Primarily pathogenic, beta-hemolytic coccal in the chains. He belongs to group A (according to Lancefield). He has a rich antigenic strukturu a tvoří mnoho extracelulárních produktů významných pro pathogenicity. Causes respiratory, skin and systemic infections. May cause sterile post-streptococcal consequences -rheumatic fever or glomerulonephritis, which may occur with untreated infections or premature discontinuationantibiotic.
Streptococcus agalactiae[edit | edit source]
Beta-hemolytic coc belonging to group B (according to Lancefield). It produces the CAMP factor, which is used in CAMP test.Asymptomatic occurrence in women in vagina can cause can cause (pneumonie, sepsis, meningitis...), which are often fatal. In older children or adults (especially immunocompromised) it may cause urinary tract infections, pharyngitis and purulent infections of surgical wounds.
Streptococcus pneumoniae[edit | edit source]
Occurs in pairs (diplococci). He is the originator pneumonia, sinusitis, otitis media, meningitis and other diseases.
Virtuating streptococci[edit | edit source]
They are a regular part of the physiological microflora of the oral cavity. These include Streptococcus mutans, S. salivarius, S. milleri, S. sanguinis and others. Streptococcus pneumoniae can also be included here.
Streptococcus mutans[edit | edit source]
It is the cause of tooth decay.
Picture gallery[edit | edit source]
Alpha-hemolytic streptococci[edit | edit source]
- Soubor:Pneumokokken.jpg
- Soubor:Streptococcus pneumoniae.jpg
- Soubor:Streptococcus mutans Gram.jpg
- Soubor:Streptococcus viridans PHIL 2897 lores.jpg
Beta-hemolytic streptococci A and B[edit | edit source]
- Soubor:Streptococcus pyogenes.jpg
- Soubor:Streptococcus agalactiae.jpg
Links[edit | edit source]
[edit | edit source]
- Streptococcal infections: Group A streptococcal infection A • Scarlet fever • Sleep angina • Erysipelas • Viral streptococcal infections • Complications and treatment of streptococcal infections • Rheumatic fever
References[edit | edit source]
References _ _ _[edit | edit source]
- ↑ JULÁK, Jaroslav. Introduction to medical bacteriology. 1st edition. Prague: Karolinum, 2006. 404 pp https://www.wikiskripta.eu/w/Speci%C3%A1ln%C3%AD:Zdroje_knih/8024612704
- BEDNÁŘ, Marek, Andrej SOUČEK and Věra FRAŇKOVÁ, et al. Medical microbiology: Bacteriology, virology, parasitology. 1st edition. Prague: Marvil, 1996. 558 pp https://www.wikiskripta.eu/w/Speci%C3%A1ln%C3%AD:Zdroje_knih/8023802976
- RYŠKOVÁ, Olga, et al. Microbiology for dentistry students. 1st edition. In Prague: Karolinum, 2004 https://www.wikiskripta.eu/w/Speci%C3%A1ln%C3%AD:Zdroje_knih/80-246-0834-0
Source[edit | edit source]
JANSKÝ, Petr. Processed questions from microbiology [online]. [feeling. 2012-02-08].https://www.yammer.com/wikiskripta.eu/uploaded_files/3804405